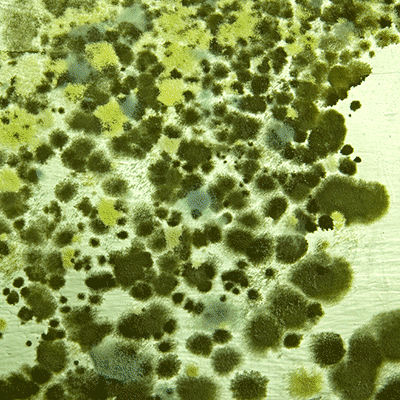

Green courses for St. Patrick’s Day
Celebrate St. Patrick’s Day with online courses that are all about green!
From mold insurance and marijuana grow ops, to money laundering, there is something for everyone in this green collection.
These green courses are CE accredited and included as part of the ILScorp CE Subscriptions!
Click below to learn more about our green courses.
General CE Subscription
Mold and Marijuana courses available as part of the 175+ courses included in the ILS General CE Course Subscription
Adjuster CE Subscription
Mold and Marijuana courses available as part of the 170+ courses included in the ILS Adjuster CE Course Subscription
Life/A&S CE Subscription
Money management courses available as part of the 70+ courses included in the ILS Life/A&S CE Course Subscription.